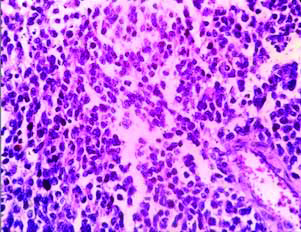

Rhabdomyosarcoma (RMS) comprises 3% of all childhood malignancy. Commonly it involves head and neck, extremity and genitourinary systems. Pure primary RMS of breast is a rare malignacy. Here, we present a case of adolescent girl presented with breast lump which was initially treated as benign lesion with excision. Again she presented with recurrent mass which was operated and microscopically showed features of small blue round cell tumour which has lead to many diagnostic confusions both clinically and histopathologically. Immunohistochemistry (IHC) with strong nuclear myogenin positivity in >50% of tumour cells confirms the diagnosis of primary mammary RMS. Postoperative period was uneventful.
Case Report
A young girl of 16-year-old had developed small mobile firm lump located in central quadrant of left breast initially. She was clinically diagnosed as fibroadenoma and excision was done. After that patient developed lump in the same breast with sudden increase in size after three weeks of excision. On examination entire breast was replaced by mass with restricted mobility. 2×2 cm left axillary node was present. Opposite breast and axilla were normal. Her complete blood count and bone marrow study was normal. There was no relevant family history.
Grossly left mastectomy specimen measuring 20×12×5 cm with elliptical skin with Nipple Areola Complex (NAC) measuring 7×5.5 cm and attached axillary pad of fat. Cut surface showed grey white infiltrative growth measuring 15×13×6 cm [Table/Fig-1]. Sections from growth, NAC, all margins and 11 nodes were submitted for histopathological examination.
Gross: cut surface shows an infiltrative grey white growth.

Microscopy showed breast parenchyma with a neoplasm arranged in sheets, lobules, nests and alveolar pattern [Table/Fig-2,3]. The tumour cells are small round with scant cytoplasm, round vesicular nucleus separated by fibrous septa seen infiltrating into the adjacent fatty tissue [Table/Fig-2,3]. Stroma showed lymphocytic infiltrate. The NAC, superior, inferior margin showed tumour infiltration. Rest of the margins and posterior margin were free. Five out of 11 nodes showed metastatic deposits with similar morphology [Table/Fig-4]. With this histology, we came to the conclusion of possibilities of small round cell tumour of breast.
Breast parenchyma with a neoplasm composed of loosely cohesive cells (H&E, 10x view).

Tumour cells are small round with scant cytoplasm with vesicular nucleus (H&E, 40x view).
Node shows metastatic deposits (H&E, 40x view).

With the histological features of small round cells arranged in dyscohesive pattern with moderate pleomorphism, following possibilities were considered:
1. Lymphoma
2. Extraskeletal Ewing Sarcoma (EES)
3. Rhabdomyosarcoma (primary/secondary)
4. Poorly differentiated carcinoma
5. Lobular carcinoma
With these differentials we proceeded with IHC. As a routine hormonal evaluation, we performed Oestrogen Receptor (ER), Progesterone Receptor (PR), Her2/Neu showed negativity. To exclude lobular carcinoma, E-cadherin was done, its negativity indicates it could be a lobular carcinoma. To confirm the epithelial origin we performed Pan Cytokeratin (CK), showed negativity excludes epithelial tumours. So, we excluded poorly differentiated and lobular carcinoma. To exclude lymphoma we did CD45, CD20, its negativity excludes lymphoma. Myogenin, CD99 were done to rule out RMS and Endometrial Stromal Sarcoma (ESS). CD99 negativity excludes EES. Myogenin showed diffuse strong nuclear positivity in 95% of tumour cells [Table/Fig-5]. But this rhabdomyosarcomatous differentiation can be a heterologus component of malignant phyllodes tumour and metaplastic carcinoma. To exclude these malignancies multiple section were taken to look for epithelial component and finally concluded with the diagnosis of RMS left breast.
Myogenin diffuse strong nuclear positivity in >95% of cells.

Furthermore, metastatic RMS is more common than primary RMS, retrospectively patient was evaluated further to look for primary elsewhere. No primary was found. So, this case was concluded as primary RMS of breast. The patient was given six cycles of second line chemotherapy. At the follow up of six months the patient continues to be disease free from the completion of the treatment.
Discussion
In adolescence primary breast malignancy is rare. Though, RMS metastasising to breast is a known malignant category with an incidence of 6.4%, primary RMS involving the breast is uncommon [1,2]. So, far hardly 15 cases have been reported in the literature [3]. Being a tertiary care centre, this is the first case reported in the past five years, determines its rarity.
Primary breast sarcoma constitutes about 1% of all malignant breast tumours [1,4]. RMS accounts for only 2% of non phyllodes sarcoma. Usually they represent a metastasis from an extra mammary site. Most common primary site being head and neck followed by extremities [5,6]. Primary mammary RMS occurs in adolescence [1,3]. More than 90% of tumours are of alveolar type. Since, primary breast malignancy is rare in this age group, there is often delay in the diagnosis [5]. So, most of the patients may develop locally advanced disease/metastasis at the time of diagnosis [3,5].
Usual presentation of mammary RMS is painless mobile mass with normal skin NAC. In such scenario, it leads to erroneous clinical diagnosis of fibroadenoma which is common in this age group. Occasionally, it may present with large irregular hard mass with overlying skin NAC ulceration. In such situation, it clinically leads to a diagnosis of malignancy, but the exact histiogenesis of malignancy cannot be arrived with clinical examination alone. Histopathology remains the gold standard investigation for accurate diagnosis.
The RMS exhibit three subtypes including alveolar, embryonal and pleomorphic subtype usually composed of small round cells with scant cytoplasm with moderate nuclear atypia. Occasional tadpole or strap cells can be present. It will be positive for myogenin, MyoD1 and desmin. Histological mimickers of RMS includes lymphoma, EES, poorly differentiated carcinoma and lobular carcinoma.
Lymphoma is characterised by singly dispersed atypical lymphoid cells, may exhibit extensive variety of histological types with diffuse large cell lymphoma being the most common. It will be positive for Leucocyte Common Antigen (LCA), CD3, and CD20 [7].
The EES is characterised by sheets, lobules or trabeculae of tumour cells which are small round cells with scant cytoplasm with round nuclei with fine chromatin with high mitotic activity. Pseudorosettes can be present. Tumour cells will be positive for vimentin and CD99 [8].
Poorly differentiated carcinoma is characterised by sheets, nests and singly scattered cells with marked pleomorphism and prominent mitotic figures.
Lobular carcinoma is characterised by small uniform round cells with moderate pleomorphism arranged in single file or targetoid pattern of non cohesive cells encircling the ducts. It will be negative for E-cadherin [9].
The IHC profile for RMS includes desmin, myogenin and MyoD1. Both MyoD1 and myogenin are highly specific and sensitive for RMS, their expression characterises cells committed to myogenesis in their earliest phase. MyoD1 is associated with non specific cytoplasmic staining, whereas myogenin tends to be a cleaner stain with less background staining. So, myogenin is better than MyoD1 for RMS [10].
All breast sarcomas should be extensively sampled to exclude malignant phyllodes tumour and metaplastic carcinoma which is common in elderly [4]. Since, RMS metastasising to breast is more common than primary RMS, all cases of RMS involving breast has to be fully evaluated to look for primary lesion [1]. Though, primary RMS has better prognosis than metastatic one, generally prognosis is worse [4]. Bone marrow is a frequent site of tumour dissemination. Bone marrow involvement indicates worse prognosis. Surgery remains the mainstay of treatment. Inoperable and cases with inadequate margin are treated with radiotherapy.
Conclusion
Primary mammary RMS are extremely uncommon, but it should be kept in mind as a possibility when dealing with breast mass in adolescence, unless there is a strong family history of breast cancer.
[1]. Achalkar GV, “Primary alveolar rhabdomyosarcoma of breast- a rare case report”J Eval Med Dent Sci 2013 2(49):9473-94.10.14260/jemds/1643 [Google Scholar] [CrossRef]
[2]. Gurubasavanagoud Y, Champaka G, Appaji L, Aruna Kumari BS, Breast metastasis from rhabdomyosarcoma: case reportInt J Health Sci Res 2013 3(5):100-03. [Google Scholar]
[3]. Pareekutty NM, Bhagat M, Vora T, Qureshi SS, Rhabdomyosarcoma of the breast: report of two cases with review of literatureJ Indian Assoc Pediatr Surg 2016 21(2):81-83.10.4103/0971-9261.17696427046981 [Google Scholar] [CrossRef] [PubMed]
[4]. Hoda SA, Koerner FC, Brogi E, Rosen PP, Rosen’s breast pathology 2014 4th edLippincott Williams and Wilkins. a Wolteers Kluwer business:1109 [Google Scholar]
[5]. Hays DM, Donaldson SS, Shimada H, Crist WM, Newton WA, Andrassy RJ, Primary and metastatic rhabdomyosarcoma in the breast: neoplasms of adolescent females, a report from the intergroup rhabdomyosarcoma studyMed Pediatr Oncol 1997 29(3):181-89.10.1002/(SICI)1096-911X(199709)29:3<181::AID-MPO4>3.0.CO;2-9 [Google Scholar] [CrossRef]
[6]. Howarth CB, Cacees JN, Pratt CB, Breast metastases in children with rhabdomyosarcomaCancer 1980 46(11):2520-24.10.1002/1097-0142(19801201)46:11<2520::AID-CNCR2820461134>3.0.CO;2-H [Google Scholar] [CrossRef]
[7]. Meddeb S, Rhim MS, Kouira M, Bibi M, Yacoubi MT, Ewing’s sarcoma: an uncommon breast tumorClin Pract 2014 4(2):65910.4081/cp.2014.65925332765 [Google Scholar] [CrossRef] [PubMed]
[8]. Brogi E, Harris NL, Lymphomas of the breast: pathology and clinical behaviorSemin Oncology 1999 26(3):357-64. [Google Scholar]
[9]. Reed AE, Kutasovic JR, Lakhani SR, Simpson PT, Invasive lobular carcinoma of the breast: morphology, biomarkers and omicsBreast Cancer Res 2015 17(1):1210.1186/s13058-015-0519-x25849106 [Google Scholar] [CrossRef] [PubMed]
[10]. Cessna MH, Zhou H, Perkins SL, Trippa SR, Layfield L, Daines C, Are myogenin or myoD1 expression specific for rhabdomyosarcoma? a study of 150 cases with emphasis on spindle cell mimicsAm J Surg Pathol 2001 25(9):1150-57.10.1097/00000478-200109000-0000511688574 [Google Scholar] [CrossRef] [PubMed]